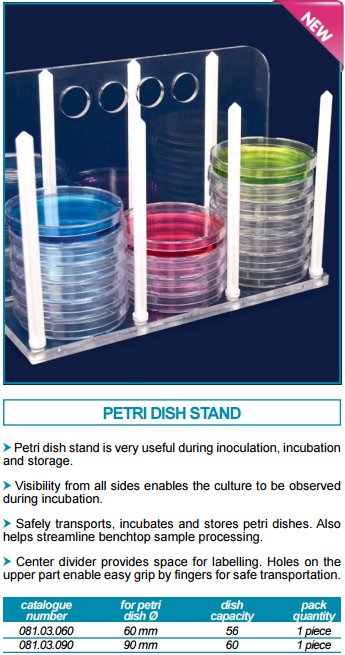

| 货号 | 名称 | 包装 | 价格单位 | 价格 | 数量 |
|---|---|---|---|---|---|
| 081.03.090 | 培养皿架- for 90 mm 培养皿 | 1支/包装 | 支 | 原价:¥730.00 现价:¥730.00 |
|
| 081.03.060 | 培养皿架- for 60 mm 培养皿 | 1支/包装 | 支 | 原价:¥811.00 现价:¥811.00 |
|
您可以联系我们的客服人员帮您找,专业的人做专业的事情,效率会更高。【德国ISOLAB】
您不可以在已经提交的订单中增减商品,您必须重新下单或者联系客服人员为您在订单中增减商品。【德国ISOLAB】
您可拨打客服热线(0535-6301185 )咨询、QQ在线客服或提交在线补货单。【德国ISOLAB】




注:若遇厂家更改包装,与商城图片、附件说明不完全一致,本商城没有及时更新的情况,请大家谅解!不论包装如何我们均确保为原厂正货!
本商城上的所有商品信息、客户评价、商品咨询、网友讨论等内容,是ISOLAB商城重要的经营资源,未经许可,禁止非法转载使用。
注:本站商品信息均来自于厂商,其真实性、准确性和合法性由信息拥有者(厂商)负责。